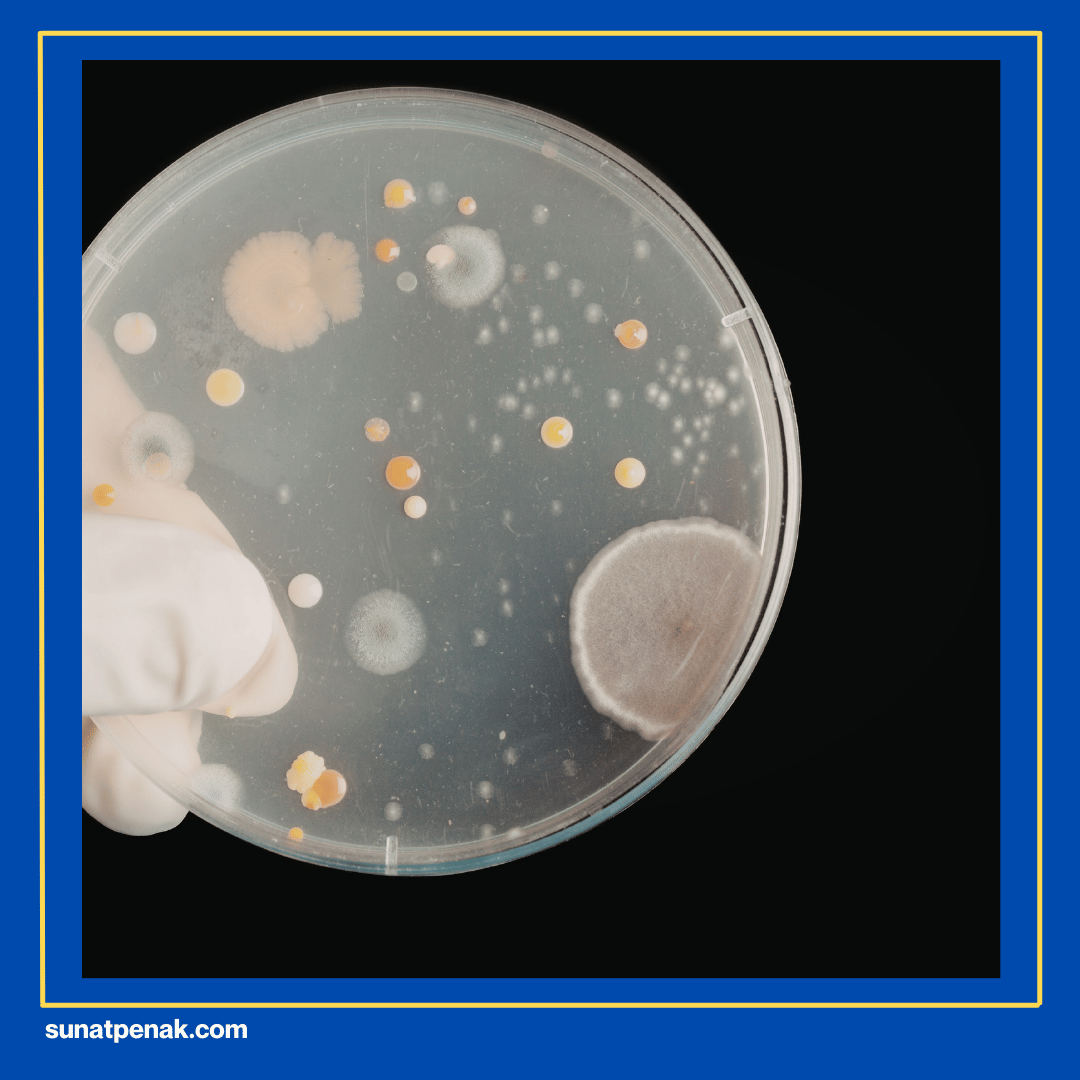
Infeksi Jamur

Sunatpenak.com – Apakah balanitis disebabkan oleh jamur? Ayah Bunda punya pertanyaan dan kekhawatiran yang serupa? Jika iya, pastikan baca informasi penting ini sampai selesai agar tidak salah paham.
Secara umum bisa dikatakan jamur termasuk salah satu penyebab utama terjadinya peradangan (balanitis) tersebut, namun bukan satu-satunya hal yang perlu menjadi perhatian Anda. Perlu Ayah Bunda ketahui kalau balanitis itu bisa timbul akibat berbagai kondisi yang berbeda-beda.
Jadi, meskipun infeksi jamur sering menjadi pemicunya, terdapat pula faktor penyebab lain yang sama pentingnya untuk dikenali. Pada kelompok tertentu, termasuk anak-anak dan pria dengan masalah kesehatan tertentu juga punya risiko lebih tinggi mengalami kondisi ini.
Beberapa ciri khas utama membantu Ayah Bunda mengidentifikasi balanitis sejak awal, terutama pada buah hati. Upaya pencegahan dan penanganan yang tepat akan mengurangi risiko serta mempercepat pemulihan. Semua penjelasan lengkapnya bisa Anda dapatkan di bawah ini.
Kelompok yang Berisiko Terkena Balanitis
Anak-anak laki-laki di bawah usia empat tahun masuk dalam kelompok berisiko tinggi terkena balanitis. Sebab, pada usia ini, kulup penis biasanya masih sulit ditarik kembali, menyebabkan area di bawahnya mudah menjadi tempat berkumpulnya kotoran dan kelembapan.
Kondisi itu memudahkan mikroorganisme seperti jamur atau bakteri untuk tumbuh dan menyebabkan peradangan. Selain itu, anak-anak yang belum terbiasa menjaga kebersihan diri mereka sendiri juga lebih rentan mengalami masalah ini.
Pria yang belum disunat memiliki risiko lebih besar terkena balanitis dibandingkan yang sudah menjalani prosedur sunat. Hal ini dikarenakan, kulup yang menutupi kepala penisnya bisa menampung smegma.
Campuran sel kulit mati, minyak, dan kelembapan akan menjadi sumber iritasi atau infeksi. Pria dengan kondisi kesehatan tertentu juga lebih mudah terkena balanitis.
Penggunaan produk yang mengandung bahan kimia keras seperti sabun berpewangi atau kondom lateks juga dapat memicu iritasi dan meningkatkan kemungkinan terjadinya balanitis.
Penyebab Kondisi Balanitis
Apakah balanitis disebabkan oleh jamur? Jawaban yang jelas adalah ya, namun kondisi peradangan pada kepala penis ini juga bisa muncul karena berbagai faktor lain yang tidak kalah penting.
Sebab, pada setiap penyebabnya memiliki ciri dan kondisi tersendiri, sehingga dengan memahaminya akan membantu Anda dalam mengenali serta menangani masalah ini dengan tepat. Berikut adalah penyebab utama balanitis secara umum!
1. Infeksi Jamur
Jamur Candida albicans adalah penyebab yang paling umum dari balanitis. Mikroorganisme ini tumbuh dengan baik di area yang hangat dan lembap, seperti area di bawah kulup pada pria yang belum disunat.
Selain itu, penderita diabetes dengan kadar gula darah tinggi lebih mudah mengalami pertumbuhan jamur yang cepat. Balanitis akibat jamur menunjukkan tanda-tanda khas, yaitu kepala penis kemerahan, rasa gatal atau terbakar, serta keluarnya cairan putih yang bergerombol.
Anak-anak dan pria dengan sistem imun lemah lebih rentan mengalami infeksi jamur ini. Kondisinya bisa menyebar dan menular ke pasangan selama hubungan intim, jika tidak ditangani. Segera lakukan pemeriksaan ketika menemukan gejala untuk mendapatkan pengobatan yang tepat.
2. Infeksi Bakteri dan Virus

Bakteri seperti jenis gram-positif atau gram-negatif juga sering menjadi penyebab balanitis, terutama pada anak-anak. Selain itu, virus seperti herpes simpleks juga bisa memicu peradangan pada kepala penis.
Kondisi kebersihan yang kurang baik menjadi faktor utama terjadinya infeksi bakteri. Terjadinya akumulasi smegma, yaitu campuran sel kulit mati dan minyak di bawah kulup menjadi tempat berkembang biaknya bakteri.
Gejala yang muncul bisa berupa kemerahan yang lebih intens, keluarnya cairan kekuningan atau bernanah, hingga munculnya luka kecil atau lepuh pada area yang terkena. Pengobatan akan disesuaikan dengan jenis mikroorganisme penyebab, mulai dari antibiotik hingga obat antivirus.
3. Iritasi dan Reaksi Alergi

Bahan kimia yang terkandung dalam produk sehari-hari sering menjadi pemicu balanitis jenis iritatif. Produk-produk yang tidak sesuai itu bisa mengiritasi kulit sensitif di sekitar kepala penis.
Kadang-kadang penggunaan sabun batang yang terlalu keras juga membuat kulit menjadi kering dan mudah meradang. Reaksi alergi atau iritasi ini biasanya muncul dalam waktu singkat setelah kontak dengan bahan penyebab.
Cara terbaik untuk menangani balanitis jenis ini yaitu dengan menghindari kontak langsung dengan pemicu iritasi atau alergi. Dokter juga mungkin meresepkan krim pelembab atau kortikosteroid ringan untuk meredakan peradangan dengan cepat.
4. Kesehatan dan Kelainan Kulit Lain

Beberapa kondisi kesehatan tertentu yang meningkatkan risiko terjadinya balanitis, salah satunya adalah diabetes. Kadar gula darah yang tidak terkontrol membuat tubuh lebih mudah terserang infeksi, termasuk pada area genital.
Selain itu, sistem imun yang lemah akibat obat-obatan tertentu atau penyakit lain juga membuat tubuh sulit melawan mikroorganisme penyebab balanitis. Kelainan kulit seperti eksim dan psoriasis juga bisa muncul pada area kepala penis dan menyebabkan peradangan.
Kondisi fimosis atau kulup yang terlalu ketat juga menjadi faktor risiko karena sulit untuk membersihkan area di bawah kulup dengan baik. Lakukan pengontrolan kadar gula darah pada diabetes, pengobatan kelainan kulit, atau bahkan melakukan prosedur sunat pada kasus fimosis akan membantu mengurangi risiko dan mencegah kekambuhan.
Pencegahan Terhadap Balanitis
Tahukah Anda, jika kebersihan yang baik adalah dasar utama pencegahan balanitis pada semua kelompok usia. Pada anak-anak, ajarkan mereka untuk membersihkan penis dengan air hangat setiap hari.
Setelah buang air kecil, tepuk kering ujung penis dengan tisu agar tidak ada sisa urine yang menyebabkan iritasi. Pria dewasa yang belum disunat bisa menarik kulup perlahan saat mandi untuk membersihkan smegma di bawahnya, lalu keringkan dengan handuk bersih dan lembut agar tidak ada kelembapan yang membantu pertumbuhan jamur atau bakteri.
Gunakan produk yang aman dan hindari zat yang bisa mengiritasi kulit sensitif di area genital. Hindari sabun berpewangi kuat, deterjen keras. Pilih celana dalam yang longgar dan terbuat dari bahan katun agar udara bisa mengalir dengan baik, mengurangi kelembapan dan gesekan yang tidak perlu.
Kelompok dengan kondisi kesehatan tertentu perlu memberikan perhatian ekstra. Penderita diabetes harus menjaga kadar gula darah stabil melalui pola makan sehat, olahraga teratur, dan mengikuti anjuran dokter, kontrol secara rutin agar tidak menciptakan lingkungan yang cocok bagi mikroorganisme.
Bagi mereka dengan sistem imun lemah, jaga kesehatan secara menyeluruh dan hindari kontak dengan sumber infeksi. Jika balanitis sering terjadi berulang, diskusikan dengan dokter mengenai pilihan prosedur sunat yang dapat membantu mengurangi risiko kondisi ini kembali muncul.
BACA JUGA : Trauma Pasca Sunat Anak
Sunat Anak Modern Terpercaya
Apakah balanitis disebabkan oleh jamur? Ya, dan salah satu cara efektif untuk mengurangi risiko kondisi ini terutama pada anak-anak dan pria yang sering mengalami kasus berulang adalah melalui prosedur sunat.
Metode sunat modern yang sekarang berkembang, menawarkan proses yang lebih aman, nyaman, dan penyembuhan lebih cepat. Prosedur sunat anak modern yang terpercaya menggunakan teknik dan peralatan yang sudah terstandarisasi serta aman.
Tenaga medis yang menangani proses ini memiliki pelatihan khusus dan pengalaman yang memadai, sehingga bisa memastikan keselamatan serta kenyamanan ananda selama dan setelah prosedur. Di sunatpenak, menyediakan layanan sunat anak modern yang aman, nyaman, dan terpercaya untuk keluarga.
Tim Sunatpenak sangat memahami kekhawatiran Ayah Bunda terhadap kesehatan ananda, sehingga tim Sunatpenak siap memberikan penjelasan detail serta panduan lengkap mulai dari persiapan sebelum prosedur hingga perawatan pasca-sunat.
Informasi lebih lanjut atau melakukan pendaftaran, Anda bisa mengunjungi website resmi Sunatpenak atau hubungi kami melalui telepon di bawah ini!
Website Resmi : sunatpenak.com
Alamat : Klinik Asy-syifa Ngadirojo Wonogiri Manggis, 1 No.11, Manggis, Ngadirojo Kidul, Kec. Ngadirojo, Kabupaten Wonogiri, Jawa Tengah 57681
Whatsapp : +6281 2264 1127


